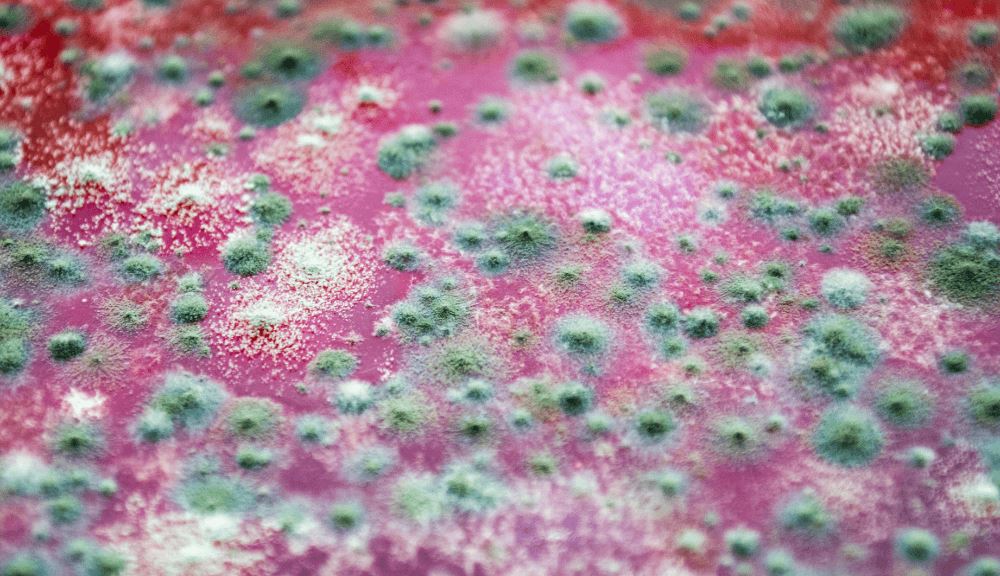

Adam's Detailing Diary
Expert Tips from the World of Auto Care

Read This Before Getting Adam’s Graphene Ceramic Spray Coating
If you’re thinking about purchasing Adam’s Graphene Ceramic Spray Coating, we’ve got the information you need to figure out whether it’s the right buy for you. We’ll cover what’s amazing about this...

Expert Guide To Cleaning Chrome Exhaust Tips Fast
While all car enthusiasts take care of the exterior of their cars, cleaning the tip of the exhaust is often overlooked. However, given the number of contaminants and wear on the exposed exhaust tip...

Choosing The Best Car Wash for a Ceramic-Coated Car
Getting a ceramic coating on your car is a liberating experience, as it significantly cuts down on car maintenance. However, understanding how to clean and protect the ceramic coating is equally im...

There Are Only 8 Steps to Detailing a Car - Let's Break Down Each
If you are planning on detailing a car, there are eight simple steps you can take. Some guides online may say that there are more than that. Detailing is an art and you could get way more complex w...

How To Get Tree Sap Off A Car Window In 5 Minutes or Less
Tree sap can be a pain, particularly when removing it from a car window. You might want to read this tutorial to learn how to remove it easily. And to help you get rid of it, we’ll even recommend o...

We Did Dashboard Protection In 5 Minutes - Here's How
Your car dashboard is more important than you think. Now, more than ever is the perfect time to give it some love!
We’ll share with you one of our favorite products that you can use in order to ke...

How to Use Snow Foam (Snow Foam for Car Washing Tutorial)
Car experts say applying snow foam is the first step in removing swirl marks and micro scratches on modern clear-coated car paint. If you’re tired of spending a fortune to keep your car clean and u...

Our Best Tricks For Protecting Your Car From Snow EVEN If You Don't Have a Garage
Winter is slowly creeping up. At this point, you might even have some snow on the ground. You might not wherever you may be.
No matter what time of year you’re reading this, it’s always good to be...

SECRET Tip For How to Get Gum Out of Car Carpet I Just Learned
You have gum stuck to the carpet of your car. It’s a real hassle and it may be difficult to remove. If you want to know how to do it with ease, we’ve got a few ideas on how to do it!
One of them w...

Adam’s Ceramic Boost Honest Review - The Tough Test
If you are planning on looking for a Ceramic Spray product, you’re in the right place. You’ll be reading our review of Adam’s Ceramic Boost and what we thought of it. We put it to good use. It’s a ...

XPEL Ceramic Boost Review - The Results Just Came In and...Wow!
If you are looking for a Ceramic Spray that will make your car shiny, then you’re in the right place. But if you are considering XPEL Ceramic Boost, we’re going to go over what’s great about it as ...

How to Get Dog Hair Out of Car Seats (Best Methods Tested)
If you’re a pet owner, you know that dealing with pet hair can be a real pain. Unfortunately, it seems like no matter what you do, dog hair finds its way into every nook and cranny of your house – ...

Make Your Car Shine Like a Diamond: The Ultimate Guide to a Shiny Ride
There’s nothing quite like the feeling of a freshly polished and shining car. The gleam in the sunlight, the sheen on the paint — it’s all so satisfying to see. But achieving that showroom shine li...
How to Get Mildew Smell Out of a Car - The Ultimate Breakdown
Maintaining a spotless and fragrant car inside makes a world of difference. Whether on a shopping run or a rural drive, the cabin becomes a little more opulent when the seats, flooring, and plastic...

How to Remove That NASTY Odor From Your Car Permanently
There’s nothing more off-putting than getting into your car and immediately noticing a unpleasant smell that stays with you on your commute. The worst part is that some car odors are incredibly dif...

What's the Best Way to Wash a Car? 3 Methods for Everyone
Washing your car is an essential part of maintaining it in top condition. While you can always go to a drive-thru car wash solution or take your vehicle to a professional detailer for car cleaning,...

After the Clay Bar What is the Next Step to a Shiny Ride?
If you want the best gloss and shine for your car, you need to clay bar your car to truly get rid of contaminants in your finish. However, you can’t just leave your car to face the elements right ...

How to Clean Car Mats - Brand New Look in Minutes!
If you’ve finally gotten around to cleaning your car’s interior, the amount of dirt and muck accumulated on your car’s mats will likely draw your attention.
Leaving the accumulated dirt and ...

Buying The Last Coat? DON'T...Before Reading This Review
Are you looking to buy ‘The Last Coat’? If so, then you want to stop for a moment. It’s important that you take a look at reviews of an all in one car polish product that has durability that you mi...

Turtlewax Ice Reviews & Alternatives - Does This Detailer Deliver?
Turtle Wax may have a longstanding reputation as one of the most recognized brands for car care and auto detailing. But is it really what it’s cracked up to be with its ‘Turtle Wax Ice’ spray? Ther...

How We Do 1-Step Paint Correction Without Any Powertools - EASIEST METHOD!
Imagine you just purchased a brand-new car that you just absolutely love. Time goes by and the more scuffs and imperfections your ride collects the more your passion fades. You’ll be amazed on how ...

The Ultimate Guide to Paint Decontamination From Start to Finish
Your car is a reflection of you. It’s the first thing people see when they meet you, and it’s important to keep it clean and polished. But what happens when your car starts to get dirty?
Dirt, br...

Rain X Waterless Car Wash Review & Alternatives 2023
Thinking about giving Rain X Waterless Car Wash a try but not sure if it’s the right product for you? You’re in the right place to get all the details and guidelines that you need to have!
Let’s ...

Leaf Stains on Car Removed In 30 Seconds With One Wicked Trick
Your car is often viewed as an extension and expression of who you are as a person. As a result, you want your car to look its best no matter the season.
While the autumn leaves are beautiful to ...

Shine Armor Review & Alternatives (Best Shine Showdown!)
Protecting your vehicle and helping it look its best are two of the biggest goals of most vehicle owners. There are a lot of products out there that are designed to help you get the job done and ke...

What is Clear Coat?...Plus One Secret To Making It Last Forever
There’s a lot of confusion surrounding clear coats, including what they are, and how to properly care for them. Some car owners are care free, thinking their clear coat is infallible and can safely...

Preparing For Everything Fall and Winter Throws At You: The Ultimate Fall Car Care Checklist
Who doesn’t love the changing seasons as the year winds down? Beautiful autumn leaves, football, and colder weather are all part of the pure excitement of fall.
However, you shouldn’t forget to ta...

Everything You Want to Know About Turtle Wax Graphene Coating
Before purchasing Turtle Wax Graphene, you may want to read this review. Not only will we go over the features, but we’ll also help you determine whether or not it’s the best option. There are plen...

15 Best Wax For Black Cars (Underrated Coatings To Try! 🧪🔬)
You have got to love how black or dark-colored cars exude sleekness and elegance.
However, anyone who has groomed a black car knows that it takes more work to keep...

21 Best Boat Wax Products That’ll Make You The Marina King
Buying a charming boat is a significant investment for all boat owners and just like all investments, keeping your boat in tip top condition is probably on the top o...

20 Best Car Drying Towels and One Stands Out as the Best
Leaving your car to drip dry in the sun or using the wrong drying towel is almost as bad as not washing it. It will leave water droplets that still contain impurities...

21 Best Tire Shines the Pros Want to Keep Secret. Shhhhh…
Many car owners overlook their tires when cleaning or detailing their cars. On the other hand, car dealers rarely make that mistake because they know just how much ...

21 Best Tire Shines the Pros Want to Keep Secret. Shhhhh…
Many car owners overlook their tires when cleaning or detailing their cars. On the other hand, car dealers rarely make that mistake because they know just how much ...

Meguiars Ultimate Compound vs Ultimate Polish + Alternatives
So, you just bought an old, classic car that has been sitting in the sun for years, and you are wondering how to restore its exterior and overall new car care. Or, ...

Glassparency Graphene Coating Review & Alternatives
Every car owner wants their vehicle to look fantastic all year long. But to do that, you often have to spend a lot of time and money maintaining your car’s outer ap...

Chemical Guys Hydroslick Review + Best Alternatives
Ceramic coatings are increasingly taking over as a car wax replacement among professionals and enthusiasts because of this new product’s many benefits. Unlike wax, t...

Chemical Guys Hydrocharge vs. Torque Detail (Who Wins)
If we lived in a utopia, all cars on the road would be eternally in automotive pristine condition, like they just rolled off the assembly line. In reality, however, ...

We Just Found The Best Way to Wash a Car Without Scratching!
Washing your car can be a great way to pass the time on a hot weekend, especially if it’s a new car. It can be a fun and relaxing zen experience for those of us wit...

📍 Graphene Coating Near Me - What to Know BEFORE You Get a Graphene Coating
One of the most popular coatings for a car on the market today is the ceramic coating which is important for car care. A close relative is the graphene coating – an...

Here’s The Best RV Wax To Use Before Your Next Adventure
When RVs are new or freshly waxed, they look outstanding; especially those with fancy decals or gel coatings. However, that can significantly change with just a few ...

18 Best Motorcycle Wax Choices to Try On Your Ride in 2023
Your chopper, moped, dirt bike, sport bike, touring motorcycle, scooter, or enduro can look even better than your pristine car, truck, van, or SUV when given the ri...

Water spots on windshield won't come off? I Just Found the Fix!
So, you have been parking your car too close to your water sprinkler or maybe your gutters have been leaking rainwater onto your car’s windshield for some time witho...

August 2022 - Shining Customers of the Month
This hot August month, Torque Detail has made car detailing fun and easy for car enthusiasts all across the US of A. We are proud to provide easy to use American-ma...

Winter Car Care: Preparing your car for the extreme cold and snow
When winter roads are perilous, as they are most of the time, it can be a great stress for a motorist to drive anywhere in the midst of a winter storm. If you have n...

Produxa vs F11 vs Torque Detail: Who Wins?
It’s a dangerous world out there for any car. One of the many disasters that could strike is none other than water damage. Or even worse, the sun’s harmful UV rays ...

How to Clay Bar a Truck: Everything You Need to Know
Like most truck owners, you want to keep your vehicle looking and running its best, so a visit to the car wash is a priority for your overall car care. A clay bar i...

Graphene vs Ceramic Coating DEMYSTIFIED! What’s The Best?
When it comes to coating your car, there are many professional grade options out there that take car care into account. You can choose vinyl, paint, or even ceramic...

303 Protectant vs Armor All + Best Alternatives in 2023
We all dream of having cars that look like we just drove them off the set of the Fast ‘n Furious movie. These cars have pristine interiors, gleaming exteriors and gi...




